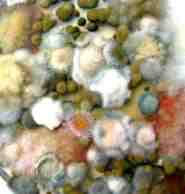

|
||||||

|
Schimmelpilze - Was ist das? |
|||||
 Syncephalastrum racemosum Schimmelpilz im Lichtmikroskop bei 400-facher Vergrößerung |
 Alternaria alternata Schimmelpilz im Mikroskop bei 400-facher Vergrößerung |
Im Zeitalter der Energieeinsparung mit dicht schließenden Fenstern und höherer Wärmedämmung kommt es zunehmend zu gesundheitsgefährdenden Belastungen in Innenräumen. Der Innenraum, sei es als Arbeitsplatz, Wohnung, Haus oder gar öffentliches Gebäude (z.B. Schulen und Kindergärten) gewinnt daher an Bedeutung als möglicher Einflussfaktor. Zunächst standen chemische Schadstoffe, wie sie aus Baustoffen ausgasen können (z.B. Formaldehyd, PCB und PCP) im Blickpunkt der Untersuchungen. Biologische Einflüsse wurden dagegen völlig unterschätzt. Inzwischen ist bei Wissenschaftlern, Forschern und Sachverständigen die Erkenntnis gereift, dass mikrobiologische Kontaminationen - wie z.B. durch Schimmelpilze - schwere Gesundheitsstörungen hervorrufen und/oder verstärken können.

Schimmelpilze auf Quark
Schimmelpilze können sich auf folgende unterschiedliche Weisen gesundheitlich auswirken:
allergene Wirkungen - hängt vom allergenen Potential der Schimmelpilzsporen ab
toxische Wirkungen - Stoffwechselprodukte von Schimmelpilzen sowie die Zellwandbestandteile (Glukane) toxisch wirken können
infektiöse Wirkungen - sie spielt vor allem bei immungeschwächten Menschen eine Rolle
Geruchsbelästigung - sie kann die Lebensqualität beträchtlich beeinflussen
Es ist eine Tatsache, dass ein signifikanter Zusammenhang zwischen Infektionskrankheiten, Allergien, Reizungen der Augen und Atemwege, sowie Müdigkeit und Gliederschmerzen etc. und dem Vorhandensein von Bakterien und verschiedenen Schimmelpilzarten in Räumlichkeiten besteht. Ein besonderes Augenmerk sollte man in diesem Zusammenhang auf Kinder richten, die noch empfindlicher als Erwachsene reagieren und ihre Beschwerden oft nicht artikulieren können. Häuser, Wohnungen und Arbeitsplätze können also krank machen.

Entnahme einer Kontaktprobe von Schimmelpilzen
Oftmals entwickelt sich Schimmelpilz im Verborgenen. Sie werden deshalb als mögliche Ursache von gesundheitlichen Beschwerden der Bewohner und Benutzer - die sehr verschieden sein können - nicht in Betracht gezogen.
Die Luft in Innenräumen ist meist wärmer und nimmt deshalb mehr Wasser als die kalte Außenluft auf. Wird diese Luft nicht ausreichend und in geeigneter Weise abgeführt, so kann sie an verschiedenen Stellen im Haus kondensieren. Hiervon sind vor allem Fensterstürze,

Raumluftmessung auf Schimmelpilze mit dem Luftkeimsammler
Raumecken, Schlafzimmerwände und Schrankrückseiten betroffen. Diese feuchten Stellen können ein idealer Nährboden für Schimmelpilze und Bakterien sein. Aber auch Möbelstücke oder ganz einfach die Tapete an der Wand. Weitere Vorkommen sind u. a. Problemstellen im Mauerwerk oder in Decken, wenn bauliche Wasserschäden (z.B. defekte Dichtung an einer Dusche) nicht sofort und intensiv getrocknet werden.
Selbst bei Verdacht auf Vorliegen eines verdeckten Schimmelpilzbefalls müssen die betroffenen Räume genauer untersucht werden. Eine solche Untersuchung setzt hohen Sachverstand voraus und sollte unbedingt durch eine dafür ausgewiesene Fachkraft durchgeführt werden. Bei Vergabe von Aufträgen hinsichtlich einer Schimmelpilzmessung sollte darauf geachtet werden, dass das Labor Qualitätssicherung betreibt und an Ringversuchen teilnimmt. Die enius hat am 5., 6. und 7. Ringversuch des Landesgesundheitsamtes Baden-Württemberg mit Erfolg teilgenommen.
Werden nach eingehender Untersuchung Schimmelpilzquellen entdeckt, muss der Ursache für den Schimmelpilzbefall nachgegangen werden. Erst danach empfiehlt es sich fachgerechte Sanierungsmaßnahmen einzuleiten. Auch hierbei ist eine fachlich kompetente Beratung erforderlich, um die richtigen Entscheidung hinsichtlich einer evtl. anstehenden Sanierung treffen zu können. Es ist nun mal nicht ausreichend, den sichtbaren Schimmelbefall oberflächlich zu bekämpfen oder einen befallenen Bereich ohne fachmännisch ausgeführte Sanierung austrocknen zu lassen, denn es muss auch häufig mit einer Gesundheitsgefährdung durch abgestorbene Mikroorganismen gerechnet werden.
Schimmelpilze einer Raumluftmessung auf einer Petrischale nach Kultivierung im Labor
Eine oberflächliche Behandlung der betroffenen Stellen kann meistens nur als vorübergehende Lösung akzeptiert und angesehen werden, wobei keine giftigen Schimmelbekämpfungsmittel (Fungizide) verwendet werden sollten. Diese eingesetzten Gifte sind für den Menschen, als auch für Tiere gesundheitsschädlich !
Eine falsche Begutachtung oder gar eine falsche Sanierung von Feuchte- bzw. Schimmelschäden wären fatal. Deshalb haben wir uns darauf spezialisiert, Schimmelpilze oder auch andere Schadstoffbelastungen in Wohn- und Arbeitsräumen aufzuspüren, die möglichen Gesundheitsgefährdungen zu beurteilen und die anstehenden Sanierungsmaßnahmen beratend und überwachend zu begleiten.
Der beste Schutz vor möglichen mikrobiellen Belastungen beginnt schon durch präventive Maßnahmen, frei nach der Devise: Vorbeugen ist besser als heilen!
( Quelle: Enius 20070110 )
